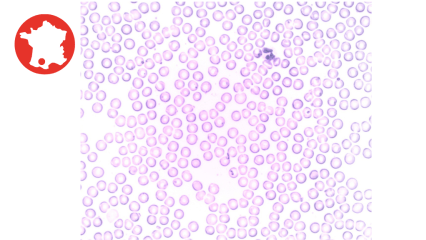

Catalogue
Vous trouverez ici toutes nos formations regroupées en 2 grandes catégories :
- formations communes aux 4 écoles
- formations de l'ENVT
Découvrez CampusVet' :
-
3
-
7
-
12
-
1
-
3
-
10
-
5
-
7
-
2